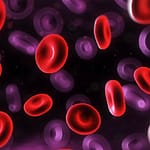
Técnicas de citogenética y biología molecular para el diagnóstico y seguimiento de la leucemia promielocítica

Revista Bioreview
Edición 125 Enero 2022
En esta edición, presentamos Técnicas de citogenética y biología molecular para el diagnóstico y seguimiento de la leucemia promielocítica, El diagnóstico de Infecciones de Transmisión Sexual por la técnica de biología molecular es la mejor estrategia para su diagnóstico oportuno y específico, entre otros temas.